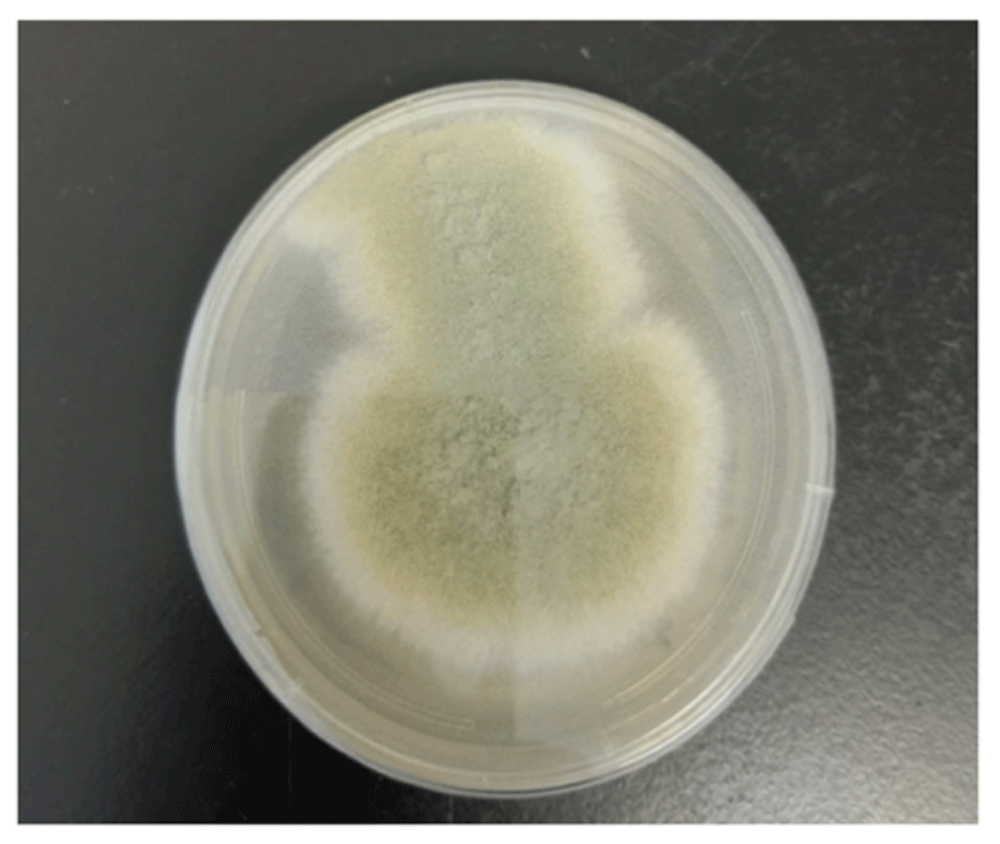
c54ff297-4f1b-4c0e-83d1-ac472ae48781_figure4a.gif
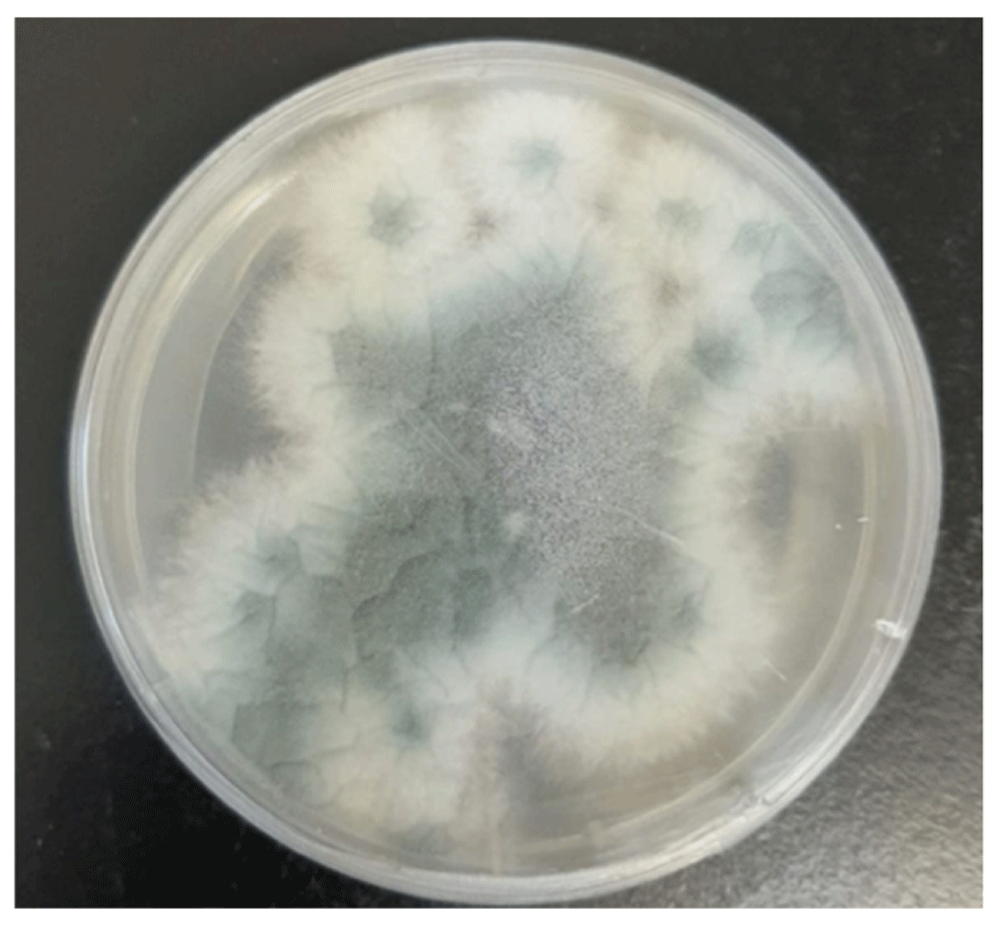
c54ff297-4f1b-4c0e-83d1-ac472ae48781_figure5a.gif

Keywords
COVID, SARS-CoV2, Aspergillosis, Invasive, Pulmonary, Critical.
This article is included in the Emerging Diseases and Outbreaks gateway.
This article is included in the Coronavirus (COVID-19) collection.
COVID, SARS-CoV2, Aspergillosis, Invasive, Pulmonary, Critical.
Invasive pulmonary aspergillosis (IPA) is typically thought to cause disease in immunocompromised hosts, particularly in neutropenic patients. In the last two decades, it has been more commonly recognized in critically ill patients, particularly those with severe acute respiratory distress syndrome (ARDS)1. An increasing number of IPA cases complicating severe influenza have been reported following the H1N1 influenza pandemic in 2009. Vanderbeke et al. described 128 cases published between 1952–20182. In late December 2019, severe acute respiratory syndrome coronavirus 2 (SARS-CoV-2) emerged as a public health emergency and has spread globally3. Co-infections among patients with coronavirus disease 2019 (COVID-19) are currently well described in the literature. Chlamydophila pneumoniae, Mycoplasma pneumoniae, and human metapneumovirus are among the common pathogens identified4. Intensive care unit admission is required in around 5–30% of patients with COVID-19. IPA has started to be recognized in severe COVID-19 infection, with multiple case series of severe COVID-19 pneumonia complicated by IPA having been reported since the start of the pandemic5–10. Here we report a case of IPA that was diagnosed in a patient with severe COVID-19 infection.
We report the case of a 29-year-old Saudi male security guard known to have diabetes mellitus and chronic kidney disease. He was admitted to hospital at the end of May 2020 as a case of COVID-19 pneumonia that was complicated with diabetic ketoacidosis and required admission to the intensive care unit (ICU). He rapidly deteriorated with progression to ARDS, requiring intubation and mechanical ventilation. He also suffered a cardiac arrest that required resuscitation for 12 minutes. He received Lopinavir/Ritonavir and Ribavirin along with Ceftriaxone in the referring hospital (dosage unknown). He was then transferred to the King Faisal Specialist Hospital and Research Centre (KFSHRC) around six days after his initial diagnosis for further management.
On day 0 of ICU admission at KFSHRC the patient was deeply sedated on intravenous (IV) propofol 150mg/hour and fentanyl 100mcg/hour, measured temperature 34.7 °C, intubated on pressure control ventilation requiring FiO2 50% and positive end-expiratory pressure (PEEP) 8 cm H2O. He required IV norepinephrine 0.02– 0.2 mcg/kg/min to maintain his mean arterial blood pressure above 65 mmHg. His blood workup on day 0 was white blood cell count (WBC) 8.28 ×109 / L (3.9–11 × 109 / L), absolute lymphocytes count 0.5 ×109 / L (1.50– 4.30 × 109 / L), platelet 54 ×109 / L (155– 435 × 109 / L), creatinine 603 umol/L (64 – 115 umol/L), and galactomannan antigen (AG) 0.48 (>0.5 reactive). A beta D-glucan test was not done as it was not available.
The patient was started on continuous renal replacement therapy (CRRT); his clinical status deteriorated with increased ventilation requirement of FiO2 50% to 80%, PEEP 8 to 16 cm H2O on day 4. A chest X-ray showed multiple bilateral ill-defined patchy opacities in the right lower lung zone (Figure 1). A computed tomography (CT) scan for his chest was done and showed multiple bilateral patchy ground-glass opacities (Figure 2, Figure 3). Bilateral lower lobe consolidations with air bronchogram showed greater involvement of the right lower lobe, while an unenhanced CT of the brain demonstrated hyperdense foci seen in the left inferior frontal, right parietal lobes with surrounding edema, and right central sulcus compatible with intra-parenchymal hemorrhage and subarachnoid hemorrhage, respectively. A follow-up MRI of the brain was obtained, showing an increased gyral pattern of T1 and FLAIR sequence, as observed in the bilateral occipital, bilateral frontal, and right parietal lobes, likely related to laminar necrosis from the anoxic- ischemic event. Gradient recalled echo (GRE) sequence showed scattered areas of blooming artifacts that are likely to be related to recent extensive hemorrhage. The brain findings were suggestive of hemorrhage and hypoxic injuries of vascular causes of previous cardiac arrest events.

The radiograph shows multiple bilateral ill-defined patchy opacities more in the right lower lung zone.

The scan shows a right middle lobe central ground-glass density with surrounding consolidation (arrow), giving the appearance of reversed halo sign 'atoll-sign'. A peripheral ground-glass density (curved arrow) is seen in the right lower lobe; a typical picture of coronavirus disease 2019 (COVID-19).

The scan shows a left lower lobe nodule (arrow) with surrounding faint ground-glass densities giving halo sign appearance.
On day 0, the patient was started on hydroxychloroquine 400mg orally every 12 hours for 1 day, followed by a maintenance dose of 200mg every 12 hours and azithromycin 500mg orally once followed by a maintenance dose of 250mg daily, respectively, for a total duration for 5 days. His antimicrobial therapy was escalated to Meropenem 0.5 gm IV every 12 hours. He continued to worsen, and thus his septic screen was repeated. His blood and urine culture remained negative.
Tracheal aspirate culture on day 0 grew Aspergillus fumigatus and Aspergillus flavus (Figure 4a, Figure 4b, Figure 5a, Figure 5b). Bronchoscopy was considered; however, it was not done due to concerns of COVID-19 transmission to the house staff. The patient was then started on dual antifungal therapy (day 4) for 1 week; Voriconazole 400mg orally every 12 hours as a loading dose, then 200mg every 12 hours as maintenance. In addition, the patient was given Caspofungin 70mg IV as a loading dose, followed by 50mg daily. After this Voriconazole monotherapy therapy (200mg orally every 12 hours) for a total duration of four weeks was completed in the hospital. One week after starting antifungal therapy (day 10 in the ICU), the secretions improved and the ventilator setting was decreased to FiO2 30%. Unfortunately, the patient on day 5 of ICU admission was found to be in a vegetative state secondary to anoxic brain damage post-cardiac arrest. The Glasgow Coma Scale was GCS 10/15 on tracheostomy.
Olive-lime green colony morphology on sabouraud’s dextrose agar.
Gray-green colony morphology on sabouraud’s dextrose agar.

Uniseriate conidiophore with columnar conidia.
The patient had a prolonged ICU stay due to infection control precaution; his stay was complicated with rhabdomyolysis, difficulty to wean him from ventilation, nosocomial infection after 30 days of ICU admission, and persistent COVID-19 virus shedding up to 73 days. The patient was then moved to a long-term facility (on day 87) after discharging him from the ICU.
This case further supports the association between IPA and severe COVID-19 infection. It highlights the importance of early diagnosis and treatment of this serious complication that can impose increased mortality. The diagnosis of IPA in patients in ICU without classical risk factors like neutropenia remains challenging1–9.
Multiple studies from China have reported different rates of Aspergillus infections among patients with COVID-19. The estimated rates of Aspergillus co-infection in these combined studies are as follows: in Jiangsu province, 60/257 (23.3%), Zhejiang province, 8/104 (7.7%); and lastly, Wuhan, 13/48 (27%). All these reported CAPA cases lack standardization in diagnostic criteria and use specific definitions to identify and define CAPA10,11. A European case series reported severe COVID-19 pneumonia complicated by IPA. All 27 cases were for patients admitted to the ICU, the majority of whom were intubated. The median duration between CAPA diagnosis and symptom onset was six days. Aspergillosis diagnosis was as early as three days post ICU admission or as late as 28 days10. Of the 27 patients, 12 (44%) received corticosteroids during their ICU stay, and 19 (70%) were treated with mould-active antifungal medication5–8. Bartoletti and colleagues found 22 (73%) of the 30 patients who were diagnosed with CAPA received Tocilizumab, and 18 (60%) received corticosteroids9.
Mixed fungal infection similar to our case was reported in two patients in a study from Pakistan, one with A. falvus and A. famigatus diagnosed as CAPA, while a second patient was thought to be colonizned with A. falvus and A. nigar12. Diagnosis is challenging due to the difficulty in differentiating between colonization and active disease in positive culture cases. Recently Arastehfar et al. suggested that galactomannan (GM) testing of bronchoalveolar fluid (BALF), or even of tracheal aspirates, may support CAPA's diagnosis11, though the test has not been validated for these specimens and cut-off values are not yet established.
Spanish tertiary hospitals carried out a retrospective study in patients with confirmed SARS-CoV-2 by PCR who isolated Aspergillus spp. in respiratory samples from bronchial aspirates (BAS) and bronchoalveolar lavages (BAL). Galactomannan assays were performed in serum and/or BAL with a cut-off index of 0.5 for both samples. COVID-19 associated IPA cases were classified according to the European Organization for Research and Treatment of Cancer/Invasive Fungal Infections Cooperative Group and the National Institute of Allergy and Infectious Diseases Mycoses Study Group EORTC/MSG criteria13 and Aspergillus algorithm for use in critically ill patients AspICU algorithm14. Aspergillus spp. were grown in ten patients from respiratory samples. Seven patients were intubated in the ICU. All isolates were detected from deep respiratory samples: eight BAS one sputum and one BAL. Galactomannan analyses were run in only three patients, one with positive values in both serum and BAL ((1.97, 3.87) and another with repeated positive values in BAL samples (2.16, 1.11). The third patient had a negative serum galactomannan test (0.22)15.
Performing bronchoscopy and obtaining a bronchial wash is challenging in patients with COVID-19. It carries a significant risk of transmission to healthcare workers, which further complicates the diagnosis of IPA in this patient population16. A surveillance strategy for fungal co-infections in intubated patients with COVID-19 was done by Brown et al.17 utilizing weekly serum1–3-β-D-glucan, galactomannan Aspergillus enzyme immunoassay (EIA) and Aspergillus PCR from bronchoalveolar lavage or endotracheal aspirates. A total of 62 patients were examined, and a galactomannan test of tracheal aspirates was performed for 85 samples; positive results were seen in six out of 62 patients, of which positive Aspergillus PCR was seen in five out of the six, and two grew Aspergillus fumigatus in culture. CAPA was clinically suspected in two patients. One of these patients’ GM from BAL was not performed. Whether galactomannan positivity of endotracheal aspirates is a marker for CAPA or reflects upper airway colonization is not clear. It should be noted that none of their cases met the definition of CAPA17.
The radiological differentiation between IPA and COVID-19 is often complex, as the radiological changes in IPA in non-neutropenic patients are diverse and non-specific. For instance, ground-glass opacities and dense consolidation are often found in COVID-19 and IPA18–20.
To the best of our knowledge, this is the first reported case of mixed fungal infection in COVID-19 in the Middle East region. This case report further supports published data about severe COVID-19 and invasive fungal infection. Diagnosis of IPA in critically ill patients with COVID-19 in ICUs remains a challenge. The difficulties we faced were that the CT chest scan showed left lower lobe nodules with surrounding faint ground-glass densities which are not sufficient to define CAPA, while tracheal aspirate cultures positive for the presence of A. fumigatus and A. flavus cannot differentiate between colonization or true invasion. Obtaining future tests from BAL to support the diagnosis is complicated by the restriction in preforming bronchoscopy in patients with COVID-19 due to the risk of aerosol generation. The accuracy of serum galactomannan to diagnose IPA would increase if consecutive tests were performed to override its poor sensitivity in IPA detection in non-neutropenic patients in ICUs. Lastly, repeated chest imaging to assess clinical response of the patient with IPA after completion of antifungal therapy unfortunately was not done, as the patient was kept on conservative and minimal intervention management.
IPA can complicate severe COVID-19 pneumonia. The diagnosis of CAPA is often challenging and requires a high index of suspicion. A constellation of clinical, biochemical, microbiological, and radiological criteria needs to be incorporated to establish the diagnosis. Timely diagnosis and management are required for better outcomes.
All data underlying the results are available as part of the article and no additional source data are required.
Written informed consent for publication of their clinical details and clinical images was obtained from the relative of the patient.
| Views | Downloads | |
|---|---|---|
| F1000Research | - | - |
|
PubMed Central
Data from PMC are received and updated monthly.
|
- | - |
Is the background of the case’s history and progression described in sufficient detail?
Yes
Are enough details provided of any physical examination and diagnostic tests, treatment given and outcomes?
Partly
Is sufficient discussion included of the importance of the findings and their relevance to future understanding of disease processes, diagnosis or treatment?
Partly
Is the case presented with sufficient detail to be useful for other practitioners?
Partly
References
1. Salmanton-García J, Sprute R, Stemler J, Bartoletti M, et al.: COVID-19–Associated Pulmonary Aspergillosis, March–August 2020. Emerging Infectious Diseases. 2021; 27 (4). Publisher Full TextCompeting Interests: No competing interests were disclosed.
Reviewer Expertise: Infectious diseases in immune compromised hosts and critically ill patients
Alongside their report, reviewers assign a status to the article:
| Invited Reviewers | ||
|---|---|---|
| 1 | 2 | |
|
Version 2 (revision) 07 May 21 |
read | |
|
Version 1 01 Feb 21 |
read | |
Provide sufficient details of any financial or non-financial competing interests to enable users to assess whether your comments might lead a reasonable person to question your impartiality. Consider the following examples, but note that this is not an exhaustive list:
Sign up for content alerts and receive a weekly or monthly email with all newly published articles
Already registered? Sign in
The email address should be the one you originally registered with F1000.
You registered with F1000 via Google, so we cannot reset your password.
To sign in, please click here.
If you still need help with your Google account password, please click here.
You registered with F1000 via Facebook, so we cannot reset your password.
To sign in, please click here.
If you still need help with your Facebook account password, please click here.
If your email address is registered with us, we will email you instructions to reset your password.
If you think you should have received this email but it has not arrived, please check your spam filters and/or contact for further assistance.
Comments on this article Comments (0)